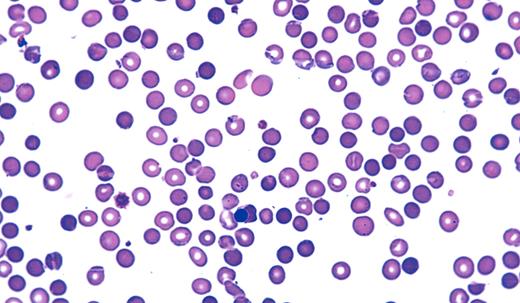
Neil Abramson, Baptist Cancer Institute

A 35-year-old woman was admitted for pleuritic chest pain. The hospitalist noted mild anemia (hemoglobin 91 g/L) and an elevated mean corpuscular volume (MCV) of 102 on the laboratory report. B12 and folic acid levels were ordered and were normal. A hematologist was requested.
The patient had 2 recent episodes of jaundice diagnosed as infectious mononucleosis. Arthralgias had also been present. The family history was negative. On examination, the spleen was palpable.
The peripheral smear showed spherocytes and a nucleated red cell. Furthermore, the elevation of MCV was related to reticulocytosis. One laboratory test was ordered: the direct Coombs test. Both the immunoglobulin G (IgG) and C3 Coombs tests were positive. A rheumatologic laboratory assessment made the patient's previous jaundice, arthralgias, and the current Coombs positive spherocytic hemolytic anemia consistent with systemic lupus erythrematosis.
Many Blood Work images are provided by the ASH IMAGE BANK, a reference and teaching tool that is continually updated with new atlas images and images of case studies. For more information or to contribute to the Image Bank, visit www.ashimagebank.org.

This feature is available to Subscribers Only
Sign In or Create an Account Close Modal